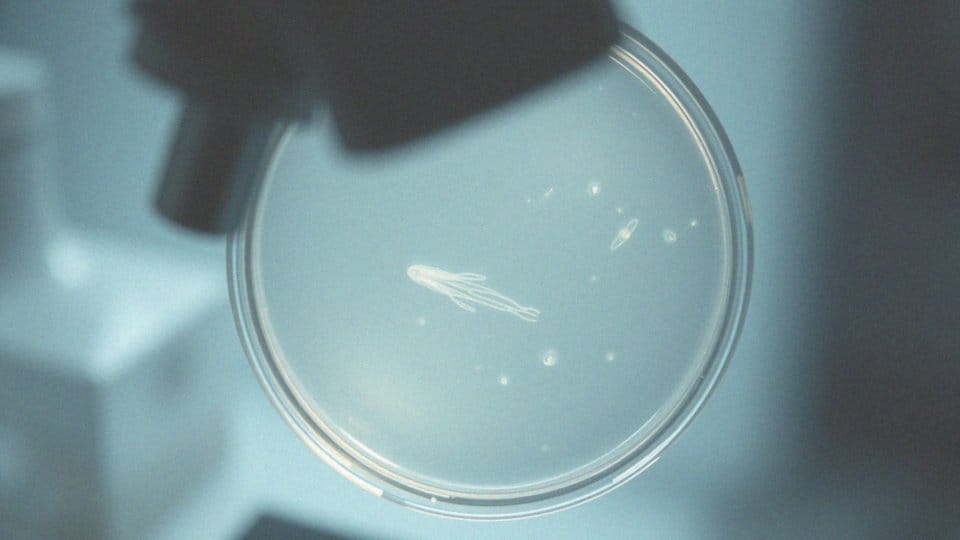

Spis treści
Co to jest martwy owsik w kale?
Znalezienie martwego owsika w kale to pozytywny znak, świadczący o skuteczności terapii przeciwpasożytniczej. Owsiki, które najczęściej zarażają dzieci, mogą być problemem, ale odpowiednie leczenie farmakologiczne skutecznie je zwalcza. Po zażyciu leków, martwe pasożyty są oczyszczane z organizmu przez układ pokarmowy. W efekcie, możemy zauważyć ich obecność w stolcu. Te preparaty eliminują pasożyty, co umożliwia ich szybkie wydalenie. Widok martwego owsika potwierdza, że terapia przyniosła efekty, co jest kluczowe dla dalszego zdrowia pacjenta.
Czym jest owsik?
Owsik to niewielki robak jelitowy, który może żyć tylko w ludzkim organizmie. Jest jednym z najczęściej spotykanych pasożytów jelitowych, a jego obecność dotyka głównie dzieci. Owsiki preferują środowisko jelita grubego, które zapewnia im idealne warunki do życia oraz rozwoju.
Ich bytowanie może prowadzić do nieprzyjemnych objawów, takich jak:
- intensywne swędzenie w okolicy odbytu,
- zwłaszcza nocą, gdy samice składają jaja.
Zakażenie następuje w głównej mierze poprzez:
- kontakt z przedmiotami, które były w kontakcie z osobami zarażonymi,
- dotyk brudnych rąk.
Infekcja owsikami jest bardzo zaraźliwa, co sprawia, że szczególna uwaga na higienę osobistą jest niezwykle ważna. Regularne mycie rąk stanowi podstawowy sposób na ochronę przed tym pasożytem. Owsiki stanowią poważny problem zdrowotny, a ich diagnoza oraz leczenie często są niezbędne. Na szczęście, dostępne terapie zwykle przynoszą pozytywne efekty, co przynosi ulgę cierpiącym.
Jakie są objawy zakażenia owsikiem?
Objawy zakażenia owsikami są łatwe do rozpoznania. Przede wszystkim intensywne swędzenie w rejonie odbytu, które nasila się w nocy, może powodować duży dyskomfort. To uczucie nie tylko utrudnia sen, ale także prowadzi do ogólnego złego samopoczucia i drażliwości. Osoby chore często uskarżają się na:
- bóle brzucha,
- nudności,
- zgrzytanie zębami podczas snu.
U dzieci warto zwrócić uwagę na zgrzytanie zębami podczas snu, co może być sygnałem do niepokoju. U dziewczynek mogą wystąpić poważniejsze problemy, takie jak zapalenie narządów płciowych czy infekcje dróg moczowych; te powikłania są wynikiem migracji owsików. Jeśli zaobserwujesz wspomniane objawy, warto niezwłocznie skonsultować się z lekarzem. Wczesne rozpoznanie i skuteczne leczenie owsicy są kluczowe, aby uniknąć dalszych komplikacji zdrowotnych. Dbanie o higienę osobistą oraz regularne monitorowanie stanu zdrowia pomogą w zapobieganiu zakażeniom.
U kogo najczęściej występuje infekcja owsikiem?
Infekcja owsikami, znana również jako owsica, najczęściej dotyka dzieci w wieku przedszkolnym oraz szkolnym. Te małe pasożyty są niezwykle zakaźne, co sprawia, że łatwo przenoszą się w miejscach, gdzie przebywa wiele osób, takich jak:
- przedszkola,
- szkoły,
- domy.
Najbardziej narażone na zarażenie są maluchy w wieku od 3 do 12 lat. Do zakażeń dochodzi często podczas wspólnej zabawy z rówieśnikami, dzielenia się jedzeniem czy korzystania z zabawek, na których mogły znajdować się jaja owsików. Niska higiena osobista, zwłaszcza niedostateczne mycie rąk, sprzyja rozprzestrzenieniu się tych organizmów. Dlatego niezwykle istotne jest, aby edukować dzieci o znaczeniu dbania o czystość. Powinny one myć ręce nie tylko po zabawie, ale także przed jedzeniem oraz po skorzystaniu z toalety. Wprowadzenie tych prostych nawyków w życie może w znaczący sposób zredukować ryzyko zakażeń owsikami.
Jak martwy owsik trafia do organizmu?
Zakażenie owsikami najczęściej następuje w wyniku spożycia ich jaj, które mogą łatwo przenosić się, zwłaszcza wśród dzieci. Te niewielkie jaja można znaleźć na:
- brudnych przedmiotach,
- dłoniach,
- osobach, które mają już taki problem.
Po dostaniu się do jelita cienkiego, jaja rozwijają się w dorosłe owsiki, które z czasem migrują do jelita grubego, gdzie składają swoje jaja. Po skutecznym leczeniu pasożytniczym organizm pozbywa się martwych osobników. Co ciekawe, jaja owsików potrafią utrzymywać się w otoczeniu przez długi czas, co sprawia, że brak odpowiedniej higieny sprzyja nawracającym zakażeniom. Dlatego po zakończeniu leczenia kluczowe jest, aby nie przestawać dbać o czystość rąk i przestrzeni, w jakiej żyjemy. Regularne mycie dłoni oraz dezynfekcja zabawek mogą znacząco zredukować ryzyko powrotu choroby.
Jak jaja owsików są przenoszone?

Jaja owsików przenoszą się głównie poprzez kontakt fekalno-oralny. Innymi słowy, zarażenie może nastąpić przez:
- bezpośredni kontakt z odchodami osób chorych,
- dostarczanie jaj do organizmu wraz z jedzeniem lub napojami,
- przenoszenie przez brudne ręce.
Kiedy ktoś drapie okolice odbytu, gdzie samice składają swoje jaja, łatwo jest przenieść je na dłonie, a następnie na inne przedmioty, takie jak zabawki czy naczynia. Dlatego tak kluczowe jest dbanie o osobistą higienę. Regularne mycie rąk stanowi istotny krok w zapobieganiu infekcjom. Warto również wiedzieć, że jaja owsików mogą unosić się w powietrzu w postaci kurzu, co jeszcze bardziej akcentuje znaczenie utrzymania czystości w otoczeniu. Autoinwazja, czyli ponowne zarażenie poprzez kontakt z własnymi jajami, często występuje, zwłaszcza u dzieci. Dla zminimalizowania ryzyka zakażeń owsikami, kluczowe jest konsekwentne dbanie o porządek. Dotyczy to zarówno naszych indywidualnych przyzwyczajeń, jak i wspólnych przestrzeni, w których przebywamy.
Jak długo martwy owsik może przetrwać w organizmach?
Martwy owsik może znajdować się w kale nawet do siedmiu dni po zakończeniu terapii. Zwykle martwe osobniki są wydalane przez nasz układ pokarmowy po przyjęciu odpowiednich leków. Warto jednak pamiętać, że jaja owsików, które mogły być w naszym otoczeniu, mają zdolność przetrwania. To z kolei podnosi ryzyko nowych zakażeń. Dlatego, mimo że pozbyliśmy się martwego pasożyta, przestrzeganie zasad higieny nadal pozostaje priorytetem.
- Regularne mycie rąk,
- dezynfekcja przedmiotów, które często używamy,
- kluczowe w walce z nawrotami infekcji.
Obecność martwego owsika jest dowodem na skuteczność leczenia, ale jednocześnie przypomina o konieczności podejmowania dalszych działań prewencyjnych. Dbajmy o naszą higienę, aby w jak największym stopniu zminimalizować ryzyko ponownego zakażenia.
Jakie leki powodują wydalanie martwego owsika w kale?
Leki pomagające w usunięciu martwych owsików z organizmu bazują głównie na preparatach przeciwpasożytniczych. Pyrantel to najczęściej stosowany środek, który paraliżuje te robaki, co znacznie ułatwia ich eliminację. Poza tym, mebendazol i albendazol również wykazują wysoką skuteczność. Działają one poprzez blokowanie wchłaniania glukozy przez pasożyty, co prowadzi do ich śmierci. Te leki są powszechnie przepisywane w przypadku owsicy, a ich efekty potwierdzają liczne badania.
Aby uniknąć nawrotów zakażeń, kluczowe jest przestrzeganie zasad higieny. Właściwe leczenie oraz troska o czystość otoczenia sprzyjają skutecznej eliminacji martwych owsików.
Jak długo martwy owsik może być wydalany po terapii?
Martwe owsiki mogą opuszczać organizm nawet siedem dni po zakończeniu leczenia. Czas ten zależy od efektywności zastosowanej terapii oraz unikalnych cech danej osoby. W przypadku pacjentów, którzy odczuli pozytywne skutki terapeutyczne, martwe owsiki są wydalane z kałem, co jest potwierdzeniem skuteczności leczenia przeciwpasożytniczego. Należy jednak mieć na uwadze, że jaja owsików potrafią przetrwać w otoczeniu przez długi czas, co znacznie zwiększa ryzyko kolejnych zakażeń.
Dlatego, choć w kale znajdują się martwe owsiki, nie można lekceważyć zasad higieny osobistej. Regularne mycie rąk odgrywa kluczową rolę w zapobieganiu nawrotom infekcji. Dodatkowo, dbałość o czystość w miejscach, gdzie bawią się dzieci, jest nieodzowna, aby uniknąć nowych zakażeń. Owsiki łatwo się rozprzestrzeniają, więc odpowiednia higiena to podstawa w walce z nimi.
Dlaczego martwy owsik może być widoczny po leczeniu?
Martwe owsiki mogą pojawić się w kale po zakończeniu leczenia z różnych powodów. Głównie jest to efekt działania leków przeciwpasożytniczych, takich jak pyrantelum, które skutecznie eliminują pasożyty z organizmu. Po ich zażyciu martwe owsiki są wydalane, co świadczy o efektywności terapii. Nie należy się trapić, gdy zauważysz martwe owsiki w stolcu – to wręcz dowód na to, że leczenie przynosi rezultaty.
Leki te oddziałują na metabolizm pasożytów, prowadząc do ich śmierci i wydalania. Warto wiedzieć, że martwe owsiki mogą być eliminowane przez kilka dni po zakończeniu kuracji. Ich obecność w kale, po przyjęciu pyrantelu, także potwierdza skuteczność zastosowanego leku.
Po terapii niezwykle istotne jest przestrzeganie zasad higieny, takich jak:
- regularne mycie rąk,
- dezynfekcja otoczenia.
Jaja owsików mogą długo przetrwać w środowisku, dlatego tak ważne są działania prewencyjne. Widok martwych owsików w kale to naturalny efekt skutecznego leczenia, który zwiększa świadomość pacjentów na temat konieczności dalszej ochrony przed zakażeniem.
Jakie są rozmiary dorosłego owsika?
Dorosłe owsiki, zwane także robakami jelitowymi, mają niewielkie rozmiary. Samice osiągają długość od 8 do 13 milimetrów, podczas gdy samce mierzą od 3 do 5 milimetrów. Mimo że są małe, ich obecność może prowadzić do poważnych problemów zdrowotnych. Wczesne rozpoznanie oraz skuteczne leczenie infekcji są niezwykle istotne, aby zredukować objawy oraz zmniejszyć ryzyko ponownego zarażenia.
Owsiki najczęściej występują u dzieci, dlatego szczególna uwaga na higienę osobistą i czystość w ich otoczeniu jest niezwykle ważna.